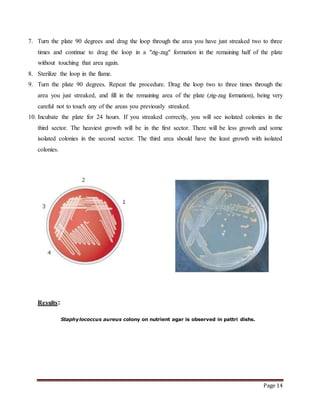
Page 14
7. Turn the plate 90 degrees and drag the loop through the area you have just streaked two to three
times and continue to drag the loop in a "zig-zag" formation in the remaining half of the plate
without touching that area again.
8. Sterilize the loop in the flame.
9. Turn the plate 90 degrees. Repeat the procedure. Drag the loop two to three times through the
area you just streaked, and fill in the remaining area of the plate (zig-zag formation), being very
careful not to touch any of the areas you previously streaked.
10. Incubate the plate for 24 hours. If you streaked correctly, you will see isolated colonies in the
third sector. The heaviest growth will be in the first sector. There will be less growth and some
isolated colonies in the second sector. The third area should have the least growth with isolated
colonies.
Results:
Staphylococcus aureus colony on nutrient agar is observed in pattri dishs.

The document summarizes the key differences between Gram positive and Gram negative bacterial cell walls. Gram positive bacteria have a thick peptidoglycan layer that retains crystal violet dye, appearing purple under a microscope. Gram negative bacteria have a thinner peptidoglycan layer and an outer membrane, causing them to appear pink after staining. The cell walls of both types of bacteria help maintain cell shape and protect the cell.




![Page 5
Buffer
A buffer is a solution containing either a weak acid and its salt or a weak base and its salt, which
is resistant to changes in pH.
OR
Buffers are the solutions which resist changes in pH when small amounts of acid or alkali is
added to them.
A buffer is a pair of weak acid and its salt.
Buffers are of main importance in regulating the pH of the body fluids and tissues
Many biochemical reactions including those catalyzed by enzymes require pH control which is
provided by buffers
Examples: Blood, TRIS buffer, phosphate buffer.
• Mammalian tissues in the resting state have a pH of about 7.4
• In order to maintain the required pH in an in vitro biochemical experiment a buffer is
always used
• The pH of a buffer is given by Handerson-Hasselbalch equation
• pH= pKa + log [A-]
[HA]
• pKa= -logKa
• Ka is the dissociation constant of the acid
• [A-] is the concentration of the base
• [HA] is the concentration of the acid
• Let we make a buffer which is described below,
• Prepare a Phosphate Buffer whose concentration is 0.1M in 250ml and it pH is 7.
As we know that Handerson-Hasselbalch equation is,
• pH= pKa + log [A-]
[HA]
Calculation;](https://image.slidesharecdn.com/acknowledgments-160213134317/85/Acknowledgments-5-320.jpg)
![Page 6
7 = 6.8 + log [salt]/ [acid]
7_6.8 = log [salt]/ [acid]
0.2 = log [salt]/ [acid]
Taking antilog on both side of the equation
Antilog [0.2] = [salt]/ [acid]
_1.609= [salt]/ [acid]
_1.609 /1= [salt]/ [acid]
_1.609 + 1= [salt] + [acid]
_0.609 = [salt] + [acid]
For Salt:
Salt = _1.609/ _0.609
Salt = 2.462
For acid:
Acid = 1 /_0.609
Acid =_1.642
Molecular weight of NaH2PO4=120
Molecular weight of Na2HPO4=142
For salt;
1M=142/1000
1M = 0.142g
For 0.1M
0.1M = 0.142/0.1
0.1M=1.42g
1000ml contain salt=1.42
1ml contain salt = 1.42/1000](https://image.slidesharecdn.com/acknowledgments-160213134317/85/Acknowledgments-6-320.jpg)
![Page 7
250ml contain salt= 1.42/1000 x250
= 0.355g
For acid;
1M=120
1M=0.12
For 0.1 M
0.1M=0.12/0.1
0.1M=1.2g
1000ml contain salt=1.2g
1ml contain salt = 1.2/1000
250ml contain salt= 1.2/1000 x250
= 0.3g
Putting the values in Handerson equation
• pH= pKa + log [A-]
[HA
7=6.8 +log 0.355/0.3
7=7
Hence prove that the pH of buffer is 7](https://image.slidesharecdn.com/acknowledgments-160213134317/85/Acknowledgments-7-320.jpg)

![Page 18
Amylase Production on Submerged Fermentation by Bacillus spp
Abstract:
The production of extracellular amylase by Bacillus spp was optimized in a submerged
fermentation. The production of the enzyme was maximum at 10 h after inoculation. The effect
of incubation period, pH of the medium and incubation temperature was optimized. The
maximum production of enzyme was obtained at 35°C and pH 7.
Introduction:
Amylases are enzymes that break down starch or glycogen. The amylases can be derived from
several sources such as plants, animals and microbes. The major advantage of using
microorganisms for production of amylases is in economical bulk production capacity and
microbes are also easy to manipulate to obtain enzymes of desired characteristics [1]. The
microbial amylases meet industrial demands a large number of them are available
commercially; and, they have almost completely replaced chemical hydrolysis of starch in starch
processing industry Although many microorganisms produce this enzyme. the most
commonly used for their industrial application are Bacillus licheniformis,: amyloliquifaciens
and Aspergillus niger. The use of the submerged culture is advantageous because of the ease of
sterilization and process control is easier to engineer in these systems. Depending on the strain
and the culture conditions, the enzyme can be constitutive or inducible, showing different
production pattern. The purpose of this work was to study the production of amylase by Bacillus
sp., in submerged cultures and optimized the cultural conditions for the production of amylase
Material and Method
Microorganism:
Bacillus spp was isolated from environment and maintained on nutrient agar slants and for every
10 days
Inoculum and Fermentation Medium:
The inoculum was prepared by the addition of sterile distilled water in the freshly grown
nutrient ager from this 0.5 ml of cell suspension was inoculated in to 100 ml of sterilized
fermentation medium and incubated at 35°C for 10 hrs. The composition of the fermentation
medium was [g/l] 6.0 g Bacteriological peptone; 0.5 g MgSO4 .7H O; 0.5 g KCl; 1.0 g Starch-,
pH 7. For inoculum media we use glucose instead of starch.
For 60ml we use these compositions of fermentation media
Bacteriological peptone = 3.6 g/60 ml](https://image.slidesharecdn.com/acknowledgments-160213134317/85/Acknowledgments-18-320.jpg)

